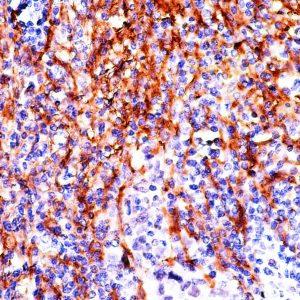
ANB95

P
Showing 21–40 of 78 resultsSorted by latest
-

Anti-p21/WAF1, Clone CIP1/4377R
Price range: $565.00 through $1,430.00 Select options This product has multiple variants. The options may be chosen on the product page -

Anti-PDGFR BETA (CD140b), Clone RM303
Price range: $269.00 through $2,740.00 Select options This product has multiple variants. The options may be chosen on the product page -

Anti-PD-L1
Price range: $250.00 through $1,319.00 Select options This product has multiple variants. The options may be chosen on the product page -

Anti-Paxillin
Price range: $250.00 through $1,139.00 Select options This product has multiple variants. The options may be chosen on the product page -

Anti-PDCD4
Price range: $250.00 through $1,475.00 Select options This product has multiple variants. The options may be chosen on the product page -

Anti-PMS2
Price range: $250.00 through $848.00 Select options This product has multiple variants. The options may be chosen on the product page -

Anti-PMS2
Read more -

Anti-PU.1
Price range: $250.00 through $1,429.00 Select options This product has multiple variants. The options may be chosen on the product page -

Anti-p27 (Kip1)
Price range: $250.00 through $1,475.00 Select options This product has multiple variants. The options may be chosen on the product page -

Anti-PSMA
Price range: $250.00 through $1,185.00 Select options This product has multiple variants. The options may be chosen on the product page -

Anti-p120 (Catenin delta 1)
Price range: $250.00 through $1,105.00 Select options This product has multiple variants. The options may be chosen on the product page -

Anti-PTEN
Price range: $250.00 through $995.90 Select options This product has multiple variants. The options may be chosen on the product page -

Anti-P53
Price range: $325.00 through $1,349.00 Select options This product has multiple variants. The options may be chosen on the product page -

Anti-PSMA
Price range: $325.00 through $995.00 Select options This product has multiple variants. The options may be chosen on the product page -

Anti-Progesterone Receptor (PR)
Read more -

Anti-Progesterone Receptor (PR)
Price range: $250.00 through $1,859.00 Select options This product has multiple variants. The options may be chosen on the product page -

Anti-P504S/AMR
Price range: $250.00 through $1,675.00 Select options This product has multiple variants. The options may be chosen on the product page -

Anti-P504S (AMACR)
Read more -

Anti-P504S (AMACR)
Price range: $250.00 through $1,675.00 Select options This product has multiple variants. The options may be chosen on the product page -
Anti-Podoplanin[PDPN/4009R]
Price range: $269.00 through $1,329.00 Select options This product has multiple variants. The options may be chosen on the product page

